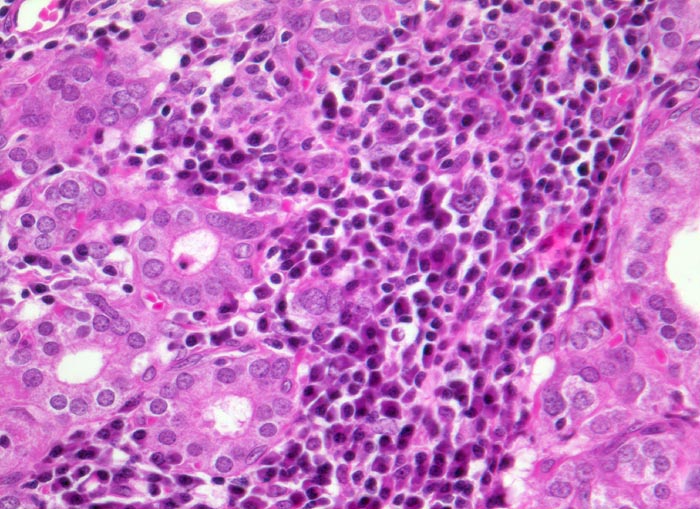

PathoPic – image database / PathoPic ID 4847 - Morbus Basedow
de
Diagnose
Morbus Basedow
Diagnose Gruppe
Systemerkrankung/Immunpathologie
Topographie
Schilddrüse
Topographie Gruppe
Endokrinium
Beschreibung
Bilder Typ
Histologie
Vergrösserung
320
Alter
42
Geschlecht
unbekannt
Datum
Ersteintrag: 11.06.2002
Update: 04.02.2024